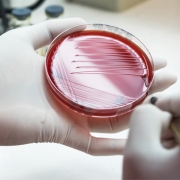
meningitis
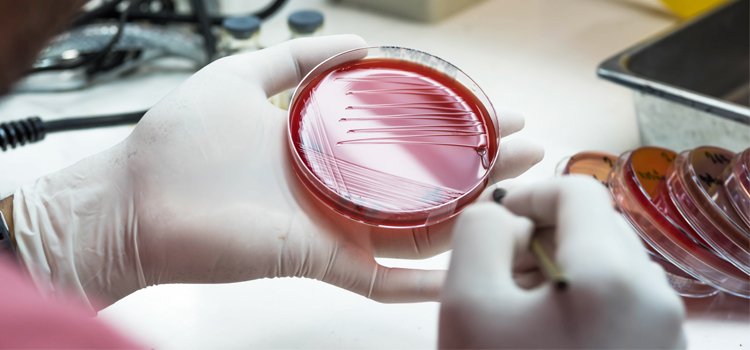

Las nuevas cepas virulentas de la meningitis
Cada año se registran alrededor de 1.000 casos de meningitis en España según datos de la Sociedad Española de Neurología. Un porcentaje alto son de origen vírico, mientras que el resto son causados por bacterias y son los más peligrosos. En los últimos años han llegado a España cepas muy virulentas de esta dolencia que puede ser mortal en los niños y adolescentes si no se diagnostica a tiempo.
¿Qué es la meningitis?
La meningitis es una dolencia que se caracteriza por la inflamación aguda de las membranas que rodean el sistema nervioso central (cerebro y médula espinal). Es difícil de detectar porque sus síntomas se asemejan mucho a un cuadro clínico de gripe:
- Dolor de cabeza intenso y continuo.
- Fiebre alta.
- Vómitos
- Manchas a la piel.
- Rigidez del cuello.
Nuevas vacunas para hacer frente al incremento de cepas virulentas de la meningitis
El año pasado se detectó un incremento de las cepas más virulentas de la meningitis, lo que provocó que la incidencia de la dolencia llegara a índices de alerta. La tasa de afectación se situó en el 1,45 por cada 100.000 habitantes. Esta cifra no tendría que superar el 1,25. Además, los profesionales advierten de que cada vez con más frecuencia la dolencia que se diagnostica pertenece a las cepas más peligrosas.
Por eso, desde el comité asesor de vacunas de la Asociación Española de Pediatría han pedido que se incluya dentro de los calendarios de vacunación de las diferentes Comunidades Autónomas una protección contra el meningococo C y concretamente contra los subtipos A, W e Y.
Factores de riesgo que facilitan el contagio por meningitis
- No vacunar los niños.
- Edad. La mayoría de los casos se dan en menores de veinte años.
- Embarazo. Esta etapa de la vida se incrementa el riesgo de listeriosis, una infección provocada por una bacteria que también puede hacer que se desarrolle meningitis.
- Sistema inmunitario débil. La diabetes, el SIDA y otras dolencias pueden incrementar el riesgo de contraer meningitis.

Dejar un comentario
Quieres comentar?Siéntete libre de contribuir